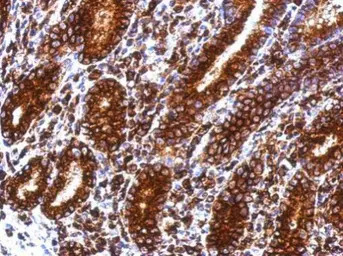
产品细节图片2

相关产品推荐更多 >
万千商家帮你免费找货
0 人在求购买到急需产品
- 详细信息
- 文献和实验
- 技术资料
- 免疫原:
Recombinant protein encompassing a sequence within the center region of human CD74. The exact sequence is proprietary.
- 亚型:
IgG
- 形态:
Liquid
- 保存条件:
Store as concentrated solution. Centrifuge briefly prior to opening vial. For short-term storage (1-2 weeks), store at 4ºC. For long-term storage, aliquot and store at -20ºC or below. Avoid multiple freeze-thaw cycles.
- 克隆性:
Polyclonal
- 标记物:
Unconjugated
- 适应物种:
Human
- 保质期:
12 months from the shipping date of the product.
- 抗原来源:
Human
- 目录编号:
GTX111929
- 级别:
Primary Antibodies
- 库存:
Available
- 供应商:
GeneTex
- 宿主:
Rabbit
- 应用范围:
WB, IHC-P
- 浓度:
1 mg/ml (Please refer to the vial label for the specific concentration.)
- 靶点:
CD74
- 抗体英文名:
CD74 antibody
- 抗体名:
CD74 抗体
- 规格:
100 μl/25 μl
| 规格: | 100 μl | 产品价格: | ¥4000.0 |
|---|---|---|---|
| 规格: | 25 μl | 产品价格: | ¥1700.0 |

Sample (30 ug of whole cell lysate)
A: Raji
B: K562
12% SDS PAGE
GTX111929 diluted at 1:1000
Immunohistochemical analysis of paraffin-embedded human colon carcinoma, using CD74(GTX111929) antibody at 1:500 dilution.
Antigen Retrieval: Trilogy™ (EDTA based, pH 8.0) buffer, 15min
风险提示:丁香通仅作为第三方平台,为商家信息发布提供平台空间。用户咨询产品时请注意保护个人信息及财产安全,合理判断,谨慎选购商品,商家和用户对交易行为负责。对于医疗器械类产品,请先查证核实企业经营资质和医疗器械产品注册证情况。
 文献和实验
文献和实验CD74 分子 CD74 常用单克隆抗体或代号: LN2,BU- 43;(li,lg ) 主要表达细胞: B,Msub [B] 分子质量(kDa)和结构: gp41/35/33,Ⅱ类相关恒定链(li链) 功 能: 与新合成MHCⅡ类分子结合,防止MHC结合内源肽 CD74 Gamma chain antigen associated with MHC class II antigen
Generation of Antibody Molecules Through Antibody Engineering
been overcome to a large extent using genetic-engineering techniques to produce chimeric mouse/human and completely human antibodies. Such an approach is particularly suitable because of the domain structure of the antibody molecule ( 2 ), where functional
The importance of antibody molecules was first recognized in the 1890s, when it was shown that immunity to tetanus and diphtheria was caused by antibodies against the bacterial exotoxins (1 ). Around the same time, it was shown that antisera
 技术资料
技术资料暂无技术资料 索取技术资料











